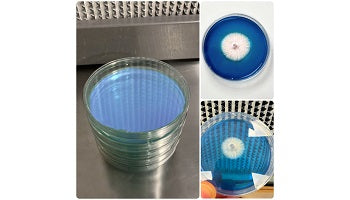

Midwest Grow Kits
Rapid Rhizo Pre-Poured Sterilized Agar Plates (5-Pack)
Rapid Rhizo Pre-Poured Sterilized Agar Plates (5-Pack)
Couldn't load pickup availability
Our Rapid Rhizo Agar plates use a custom blend of nutrients and yeasts that trigger faster and aggressive rhizomorphic (thread-like) growth. In mycology, there are a few different steps and goals when working with agar plates in mycology. Cleaning or ensuring your sample is free from other molds or bacteria and isolating the strongest genetics. Once you have ensured your sample is clean, you want to transfer the strongest genetics to a new plate. Our Rapid Rhizo Agar plates are great for identifying the strongest genetics or showcasing your isolated strain in the final transfer.
Our agar plates are made fresh daily! Most pre-poured agar plates sit for weeks before shipping. See the difference fresh makes! Each set of 5 plates are sealed in polyolefin packaging.
Features & Includes:
- 5 Sterilized Rapid Rhizo Nutrient Blend Agar plates
- 90mm Polystyrene Petri Dishes
- Made with perfect blend of ingredients to promote fast, rhizomorphic growth.
- Pressure sterilized & Poured in our lab using laminar flow hood
- Please store agar plates in the fridge and use within 3-4 weeks for optimal results
Share